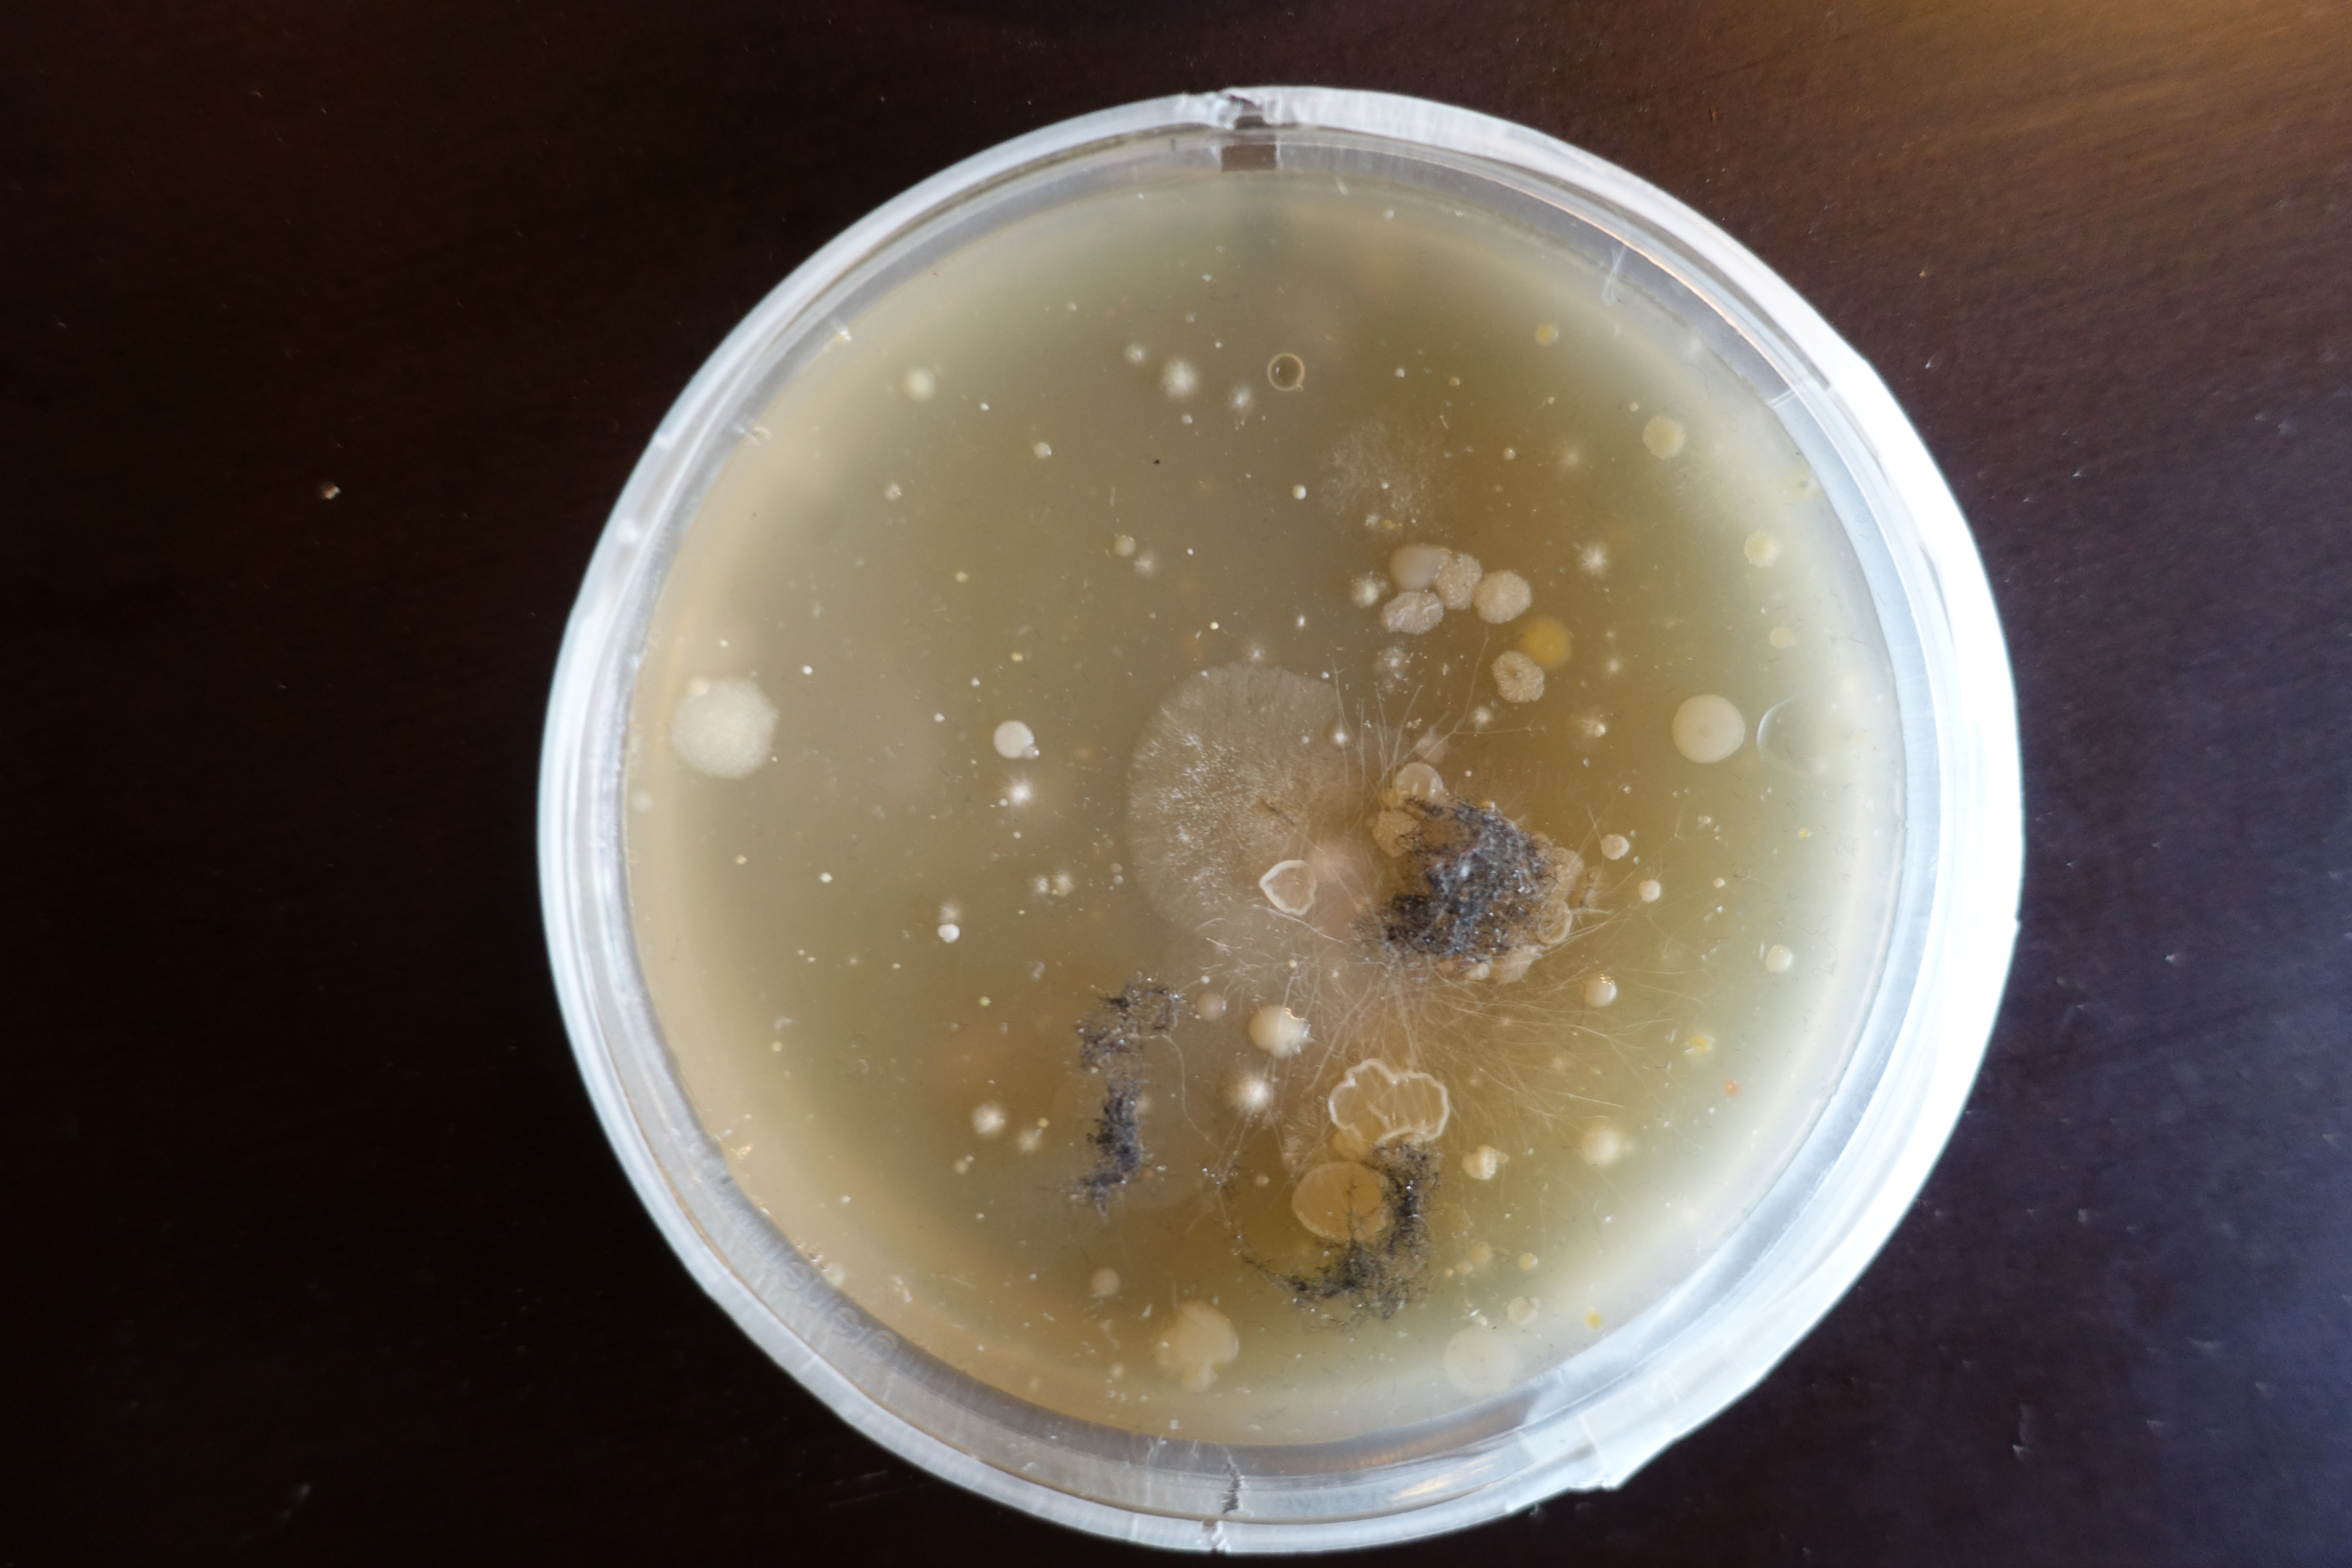

taro
particula influxus
Biomonitors
Fri, 10. Sept, 18:00-24:00
Sat, 11. Sept, 08:00-24:00
Sun, 12. Sept, 08:00-18:00
Workshop-Space

be aware of your (invisible) environment
-STREAMING material content..
-COLLECTING/STORING momentary samples of airborne particles..
-MONITORING/VISUALIZING/GROWING the LOCAL MICROBIOMEˣ…
by the means of an ELECTROSTATIC PARTICLE STREAMER/SAMPLERʸ and several BIO-MONITORSᶻ
ˣ microbiome definition re-visited: old concepts and new challenges (2020):
the microbiome is defined as a characteristic microbial community occupying a reasonably well-defined habitat (…) the microbiome not only refers to the microorganisms involved but also encompasses their theatre of activity (…) the microbiome forms a dynamic and interactive micro-ecosystem prone to change in time and scale.
ʸ = DIY: ventilator (as streamer) + high voltage circuit (to create an electrostatic surface) + controller
ᶻ = petri dishes filled with M(alt)E(xtract)A(gar): plain MEA to show the totality of (local)microbial life + antibiotic MEA to focus on our (local)fungal cohabitants
The work was shown in the summer of 2021 at electropixel 11 at Plateforme Intermédia in Nantes/F, as part of an APO33 and STWST Exchange.
taro klemens knopp (at), working, observing, researching, experimenting, playing [with] the fringes of science, art, politics, life, realities,.. dealing with living organisms – especially fungi – as a medium of art. also co-founder of messschiff eleonore, habiTAT tenement syndicate, willy*fred houseproject, MyceliumNetworkSociety…
DOCUMENTATION:







